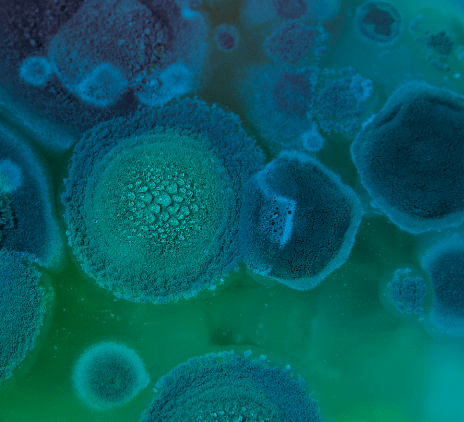
Biotechnology

The Life Sciences sector has never been more important or more in the public eye.
Filter insights by:
Showing 11 of 23 content results
Australia has a reputation as one of the world’s leading destinations for life sciences, developing life-changing innovations that have real social benefit – from the world’s first anti-cancer vaccine to spray-on skin for burns victims.
The 2019 Biotechnology Industry Position survey conducted by Ausbiotech and supported by Grant Thornton has revealed that new technologies across regenerative medicine and medicinal cannabis are disrupting the industry, and Australia's global strength in clinical trials continues to drive contributions to the economic and social fabric of the country.
Australia has a successful, clear and robust R&D support program. With no additional investment in R&D from the Federal Budget...
With cybersecurity attacks becoming increasingly sophisticated, one of the biggest challenges for companies is to...
This is the eighth Biotechnology Industry Position Survey conducted by AusBiotech and supported by Grant Thornton. The 2018 Survey reveals the strongest ever business sentiment across the sector.
The Australian biotechnology sector was looking for two things from this year’s budget — the retention of the R & D Tax Incentive and some certainty about future Government funding.
The year was the strongest on record for the biotechnology sector but its leaders remain concerned over the fate of the R&D Tax Incentive.
The 2016 Biotechnology Industry Position Survey reveals that Australian life sciences companies have attracted well over $2 billion in deal flow over the last 18 months.
2015 Biotechnology Industry Position Report Respondents to the fifth annual biotech survey were the most positive they have been regarding how their companies performed with 69% reporting a good or excellent year.
Grant Thornton looks at the potential impact of IFRS 15 'Revenue from Contracts with Customers' for revenue recognition in the life sciences industry.